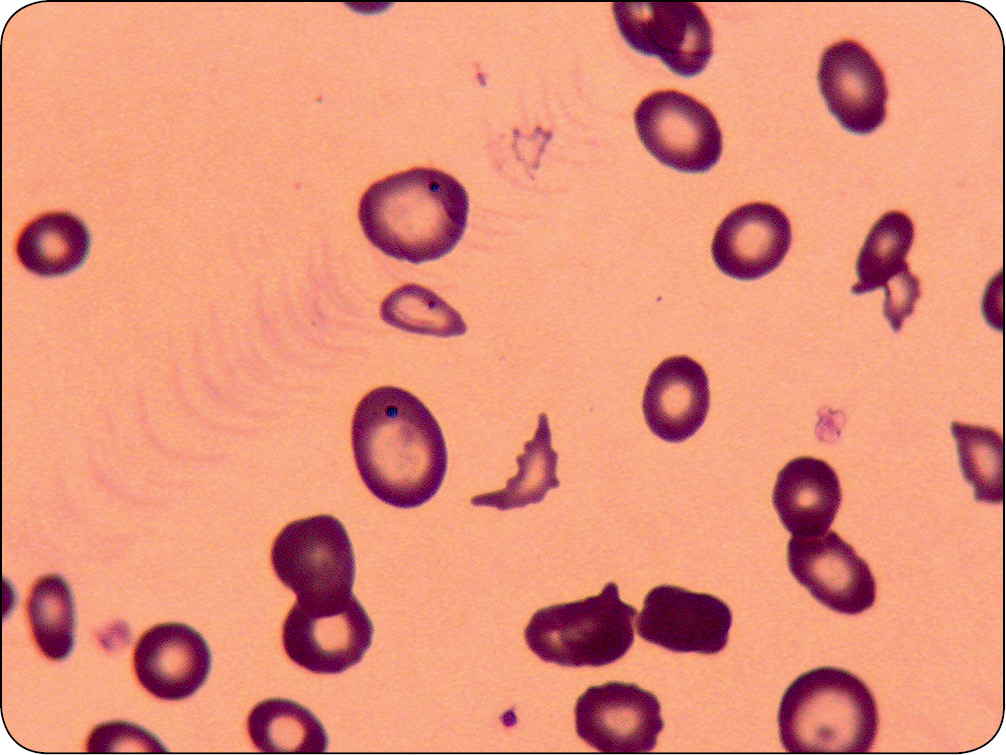
WWP_10_11_Janina_Lukaszewska_ZESPOLY_PARANOWOTWOROWE_RYC_7

Zespoły paranowotworowe Trudne przypadki
Zwłóknienie szpiku kostnego (mielofibroza)
Mielofibroza zaliczana jest do zespołów rozrostowych szpiku kostnego. Może być pierwotna (idiopatyczna) lub wtórna, a wśród przyczyn wymienia się między innymi procesy nowotworowe (chłoniaki, białaczki, także nowotwory w innych narządach) lub przewlekłe anemie hemolityczne, ale często mogą być one nieznane. Weiss i wsp. (19) opisują w swojej pracy trzy przypadki wtórnego zwłóknienia szpiku kostnego, towarzyszące chłoniakowi, rakowi płuc, śledziony i wątroby oraz mięsakowi gruczołu krokowego. Charakteryzuje się ona nadmierną proliferacją fibroblastów w szpiku, jego włóknieniem i następowym tworzeniem dodatkowych ognisk hematopoetycznych. Towarzyszy jej niedokrwistość nieregeneratywna, erytroblastoza, splenomegalia, a w obrazie krwinek czerwonych występuje znaczna poikilocytoza. Szczególnie charakterystyczna jest obecność erytrocytów w kształcie łzy – lakrimocyty oraz owalocytów (ryc. 7, str. 44) (6, 16, 19, 21).
Może być ona przyczyną wtórnej dysplazji szpiku kostnego. Charakteryzuje się obniżeniem liczby erytrocytów, granulocytów lub trombocytów we krwi obwodowej wskutek zaburzeń ich wytwarzania i dojrzewania w szpiku kostnym. Cytopenia może dotyczyć jednej linii komórek produkowanych w szpiku kostnym, dwóch linii lub trzech – pancytopenia (erytrocytów, granulocytów obojętnochłonnych, płytek krwi). Równocześnie występują znaczne zaburzenia w ich morfologii. Niedokrwistości występujące w tych zespołach mają charakter nieregeneratywny oraz długotrwały przebieg, tak jak w opisanym poniżej przypadku (8, 20).
[...]
którzy są subskrybentami naszego portalu.
i ciesz się dostępem do bazy merytorycznej wiedzy!
POSTĘPOWANIA
w weterynarii






















